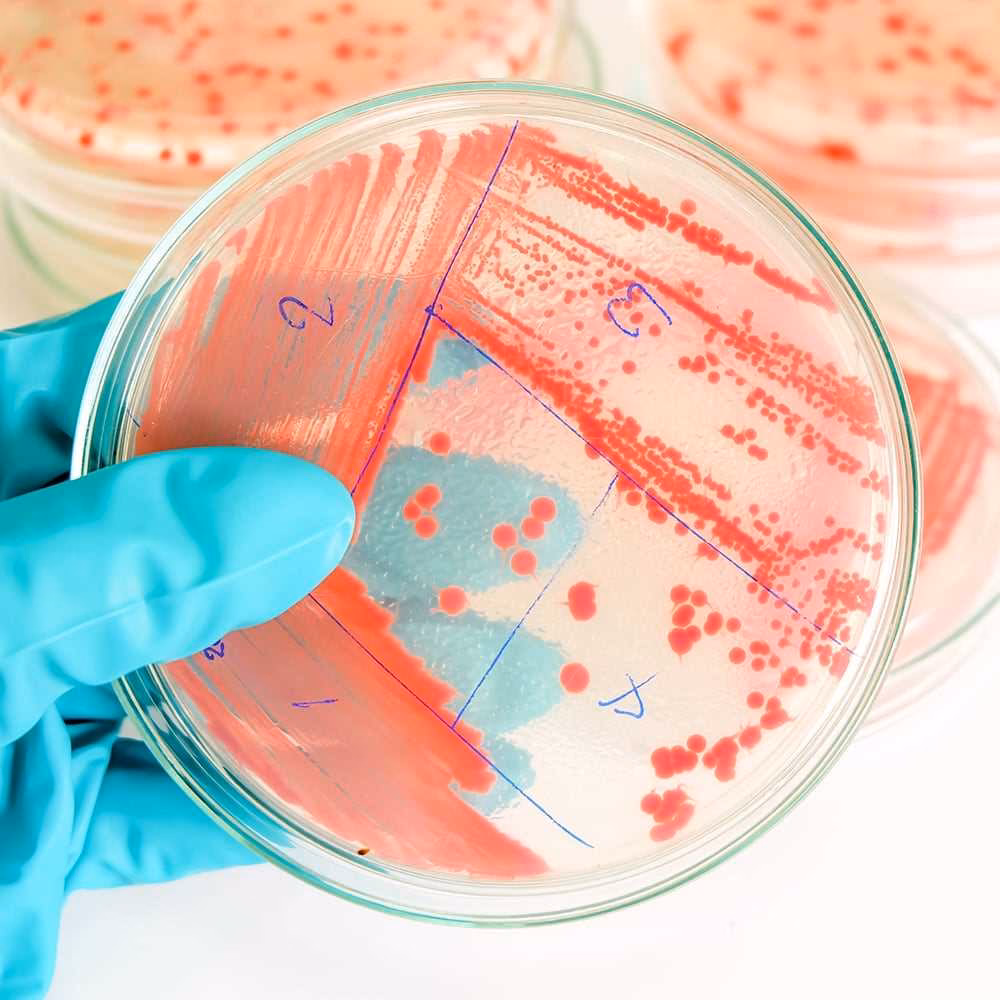
¿Por qué estudiar microbiología?

16/01/2025
En un mundo donde lo invisible a menudo tiene el mayor impacto, la microbiología se erige como una de las disciplinas científicas más vitales y fascinantes. Desde la salud humana hasta la sostenibilidad del planeta, los microorganismos —bacterias, virus, hongos, algas microscópicas y protozoos— son los arquitectos silenciosos de la vida tal como la conocemos. Estudiar microbiología no es solo aprender sobre estos seres diminutos, es embarcarse en un viaje de descubrimiento que te permitirá comprender y, lo que es más importante, influir en los procesos fundamentales que sustentan nuestro mundo.

¿Qué es la Microbiología y Por Qué es Tan Relevante Hoy?
La microbiología es la rama de la biología dedicada al estudio de los microorganismos, entidades biológicas de tamaño microscópico que no pueden ser vistas a simple vista. Abarca su morfología, fisiología, genética, ecología y su impacto en otros seres vivos y en el medio ambiente. Su relevancia se ha disparado en las últimas décadas debido a la creciente comprensión de su papel crucial en casi todos los aspectos de la vida. Desde la pandemia de COVID-19, que puso de manifiesto la urgencia de la virología, hasta la crisis climática, donde los microbios juegan un rol fundamental en los ciclos biogeoquímicos, la microbiología está en el centro de los mayores desafíos y oportunidades de nuestro tiempo.
Un Vistazo a los Campos de Aplicación de la Microbiología
La amplitud de la microbiología es asombrosa, con aplicaciones que tocan prácticamente todos los sectores. Aquí te presentamos algunos de los más destacados:
Salud y Medicina: Guardianes de Nuestro Bienestar
Este es quizás el campo más conocido. Los microbiólogos son esenciales en la lucha contra las enfermedades infecciosas. Investigan patógenos, desarrollan vacunas y antibióticos, y trabajan en el diagnóstico y la prevención de epidemias. También exploran el microbioma humano, esa vasta comunidad de microorganismos que viven en y sobre nosotros, y su profunda influencia en nuestra salud, desde la digestión hasta el sistema inmune y la salud mental. El estudio de la resistencia a los antimicrobianos, una de las mayores amenazas para la salud global, es también un pilar fundamental de esta área.
Medio Ambiente: Los Ingenieros del Planeta
Los microorganismos son los principales impulsores de los ciclos biogeoquímicos (carbono, nitrógeno, azufre, etc.) que mantienen la vida en la Tierra. En este campo, los microbiólogos estudian cómo los microbios pueden ser utilizados para la biorremediación, limpiando derrames de petróleo, contaminantes y residuos tóxicos. También investigan su papel en la producción de biocombustibles, la gestión de aguas residuales y su impacto en el cambio climático, como la producción de gases de efecto invernadero o la captura de carbono.
Alimentos y Agricultura: De la Granja a la Mesa
¿Alguna vez te has preguntado cómo se hace el pan, el queso, la cerveza o el yogur? Detrás de ellos hay procesos de fermentación mediado por microorganismos. Los microbiólogos alimentarios aseguran la seguridad de nuestros alimentos, previniendo la contaminación y el deterioro. En agricultura, estudian cómo los microbios del suelo pueden mejorar la fertilidad, promover el crecimiento de las plantas y protegerlas de enfermedades, reduciendo la necesidad de pesticidas químicos. Esto es crucial para la sostenibilidad alimentaria global.
Industria y Biotecnología: Innovación Sin Límites
La biotecnología microbiana está revolucionando la producción industrial. Los microorganismos son utilizados como "fábricas" microscópicas para producir una vasta gama de productos: enzimas para detergentes, vitaminas, aminoácidos, bioplásticos, productos farmacéuticos y más. La ingeniería genética microbiana permite diseñar microorganismos con capacidades específicas para procesos industriales más eficientes y sostenibles.
Habilidades Clave Desarrolladas al Estudiar Microbiología
Una carrera en microbiología no solo te dota de conocimientos especializados, sino que también fomenta un conjunto de habilidades altamente valoradas en cualquier campo profesional:
- Pensamiento Crítico y Analítico: La capacidad de analizar datos complejos, interpretar resultados experimentales y resolver problemas.
- Habilidades de Laboratorio: Destreza en técnicas asépticas, cultivo de microorganismos, microscopía, biología molecular y bioquímica.
- Resolución de Problemas: Identificar y abordar desafíos científicos y prácticos.
- Comunicación Científica: Presentar hallazgos de manera clara y concisa, tanto oralmente como por escrito.
- Trabajo en Equipo: Colaborar eficazmente en entornos de investigación y desarrollo.
- Atención al Detalle: Fundamental para la precisión en el laboratorio y la interpretación de resultados.
¿Es la Microbiología la Carrera para Ti?
Si eres una persona con una curiosidad insaciable por el mundo natural, si te intriga cómo funcionan las cosas a nivel fundamental y si te apasiona la idea de contribuir a soluciones para los problemas más grandes de la humanidad, entonces la microbiología podría ser tu vocación. Es una carrera para mentes inquisitivas, pacientes y metódicas, dispuestas a pasar horas en el laboratorio observando lo que es invisible a simple vista, pero con un impacto macroscópico.
Para ilustrar la diversidad de este campo, aquí te presentamos una tabla comparativa de algunas de las ramas principales de la microbiología:
| Rama de la Microbiología | Enfoque Principal | Ejemplos de Aplicación |
|---|---|---|
| Bacteriología | Estudio de las bacterias. | Desarrollo de antibióticos, identificación de patógenos bacterianos, estudio del microbioma intestinal. |
| Virología | Estudio de los virus. | Desarrollo de vacunas antivirales, investigación de pandemias (ej. COVID-19, VIH), terapia génica. |
| Micología | Estudio de los hongos (incluyendo levaduras y mohos). | Producción de penicilina, estudio de infecciones fúngicas, fermentación de alimentos. |
| Parasitología | Estudio de parásitos (muchos de ellos protozoos microscópicos). | Diagnóstico y tratamiento de malaria, enfermedad de Chagas, giardiasis. |
| Inmunología | Estudio del sistema inmune y su respuesta a los microorganismos. | Desarrollo de inmunoterapias, vacunas, comprensión de alergias y enfermedades autoinmunes. |
| Microbiología Ambiental | Estudio de los microorganismos en sus entornos naturales. | Biorremediación, ciclos biogeoquímicos, producción de biocombustibles. |
| Microbiología de Alimentos | Estudio de los microorganismos en la producción y seguridad alimentaria. | Control de calidad alimentaria, desarrollo de probióticos, procesos de fermentación. |
Preguntas Frecuentes sobre la Carrera de Microbiología
¿Qué requisitos académicos se necesitan para estudiar microbiología?
Generalmente, se requiere un buen rendimiento en ciencias (biología, química, física y matemáticas) a nivel de bachillerato. Muchas universidades ofrecen programas de pregrado en Microbiología, Biología con énfasis en Microbiología o carreras afines. Luego, es común continuar con estudios de posgrado (maestría, doctorado) para especializarse en un área específica y dedicarse a la investigación.
¿Dónde puede trabajar un microbiólogo?
Las oportunidades laborales son diversas:
- Laboratorios Clínicos: Diagnóstico de enfermedades infecciosas.
- Industria Farmacéutica: Desarrollo de fármacos, vacunas y antibióticos.
- Industria Alimentaria: Control de calidad, desarrollo de nuevos productos fermentados.
- Laboratorios de Investigación: Universidades, centros de investigación gubernamentales o privados.
- Salud Pública: Vigilancia epidemiológica, control de brotes.
- Industria Biotecnológica: Producción de enzimas, bioplásticos, biocombustibles.
- Sector Ambiental: Biorremediación, tratamiento de aguas.
- Agricultura: Salud del suelo, desarrollo de biofertilizantes.
¿Es una carrera con futuro?
Absolutamente. Dada la creciente importancia de la salud global, la sostenibilidad ambiental y la innovación biotecnológica, la demanda de microbiólogos es y seguirá siendo alta. Es una carrera que se adapta y evoluciona constantemente con los nuevos desafíos y descubrimientos científicos.
¿Qué diferencia hay entre microbiología y biología general?
La biología general es un campo muy amplio que estudia todos los aspectos de la vida, desde las moléculas hasta los ecosistemas. La microbiología es una subdisciplina especializada de la biología que se enfoca exclusivamente en los organismos microscópicos. Un biólogo general tiene una base amplia, mientras que un microbiólogo tiene un conocimiento profundo y especializado en el mundo microbiano.
¿Es muy difícil la carrera de microbiología?
Como cualquier carrera científica, la microbiología requiere dedicación, estudio constante y una mente curiosa. Implica conceptos complejos y técnicas de laboratorio precisas. Sin embargo, con interés y esfuerzo, es completamente manejable y extremadamente gratificante. La dificultad es subjetiva y a menudo se ve superada por la pasión por el descubrimiento.
En conclusión, la microbiología es mucho más que una disciplina académica; es una ventana a un universo invisible que impacta cada faceta de nuestra existencia. Estudiarla es elegir una carrera con un propósito claro: desentrañar los secretos de la vida más pequeña para resolver los desafíos más grandes de la humanidad. Es una inversión en tu futuro y en el futuro del planeta, una elección que te permitirá ser parte de la innovación y el progreso científico. Si buscas una profesión que te desafíe, te inspire y te permita hacer una diferencia real, el fascinante mundo de la microbiología te espera.
Si quieres conocer otros artículos parecidos a Descubre el Universo Invisible: ¿Por Qué Estudiar Microbiología? puedes visitar la categoría Librerías.

